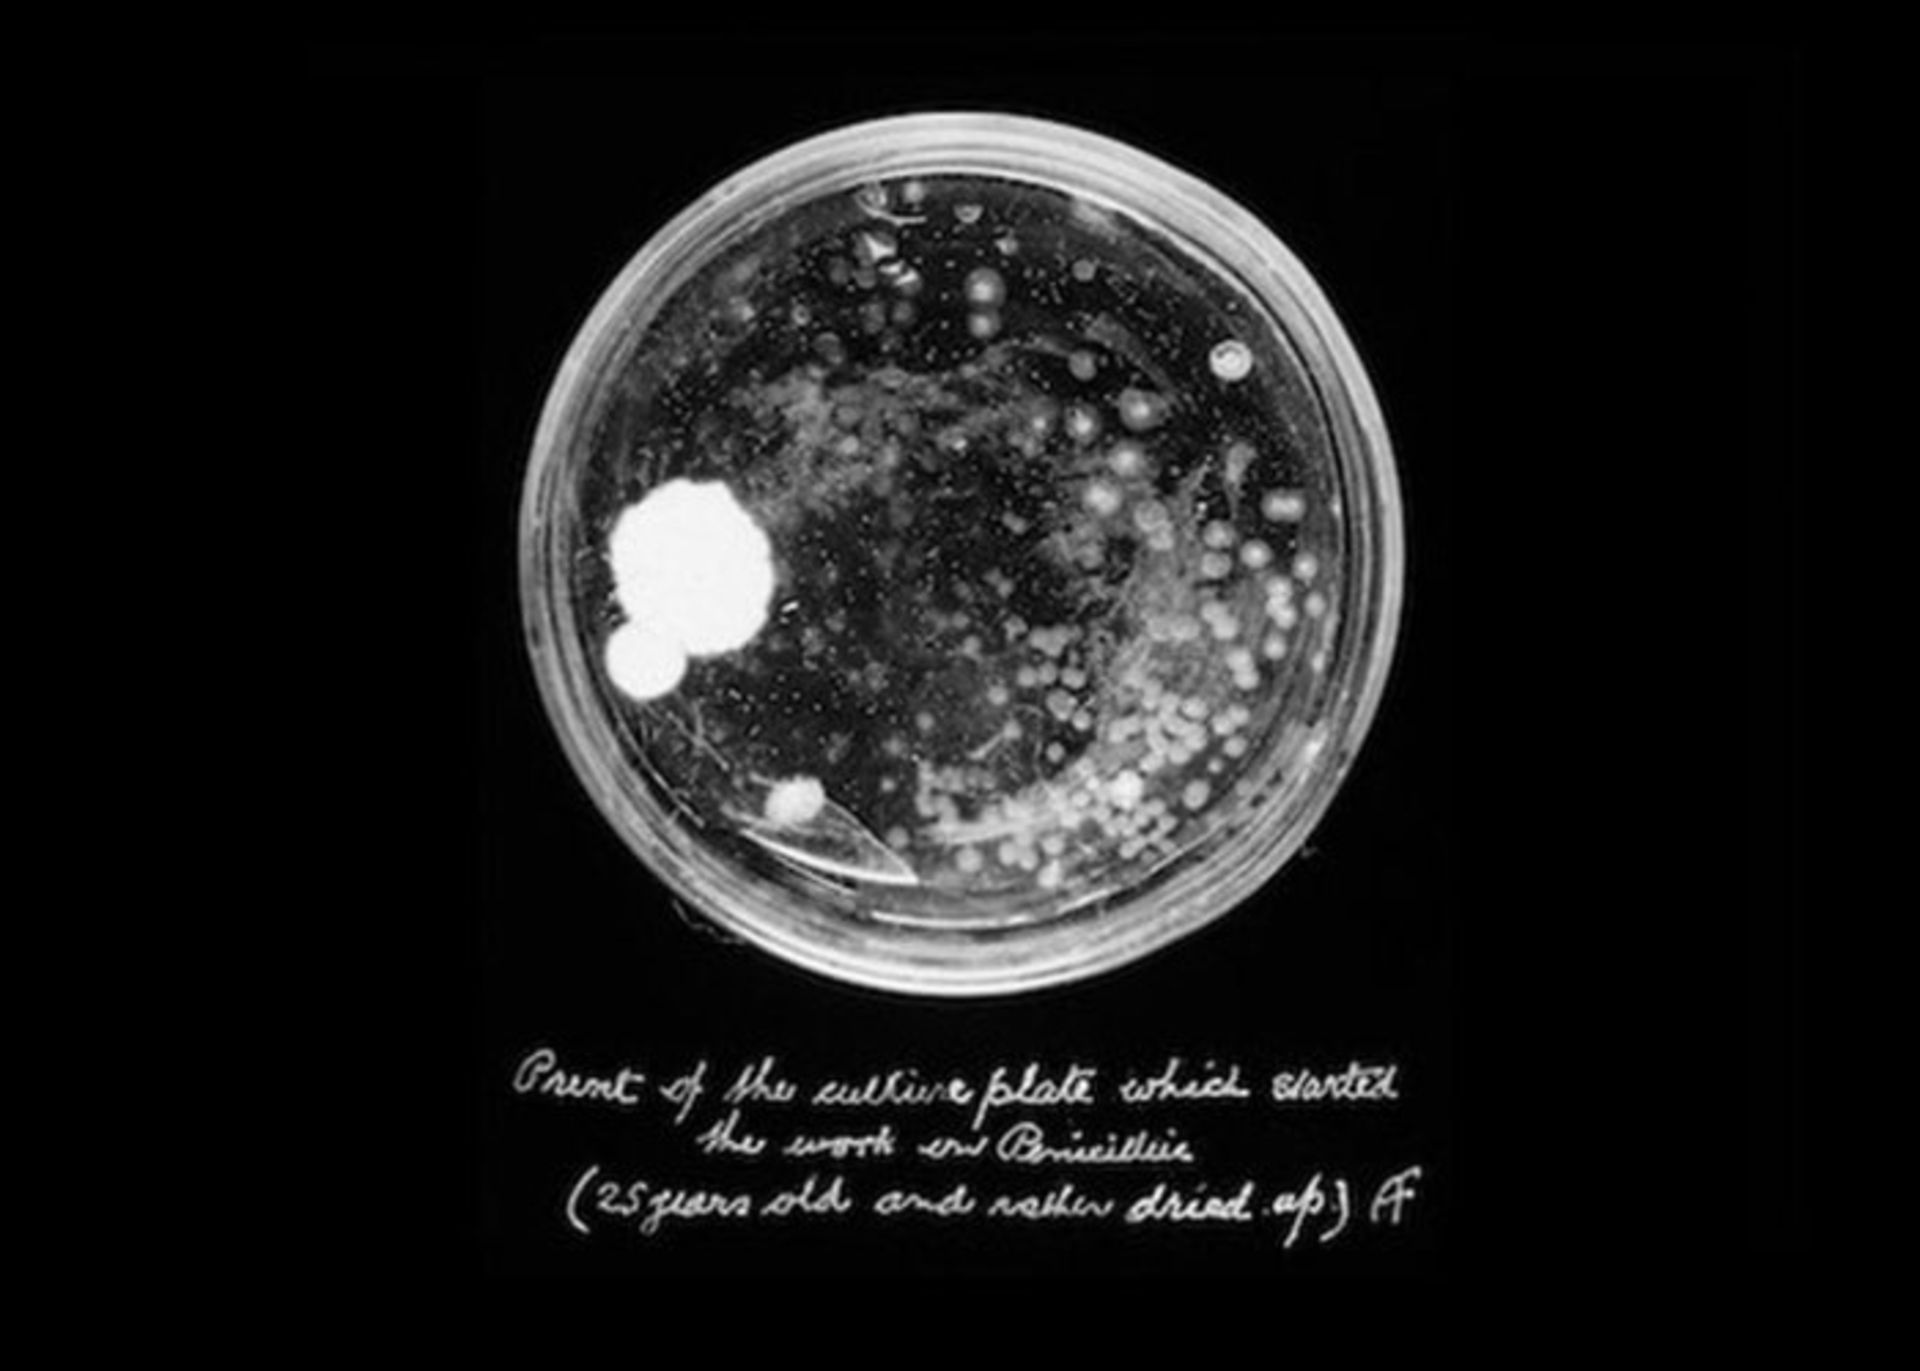
پتری دیش فلمینگ

مقاومت دارویی باکتریها و کشف راهی جدید برای مقابله با آن

صبح روز سوم سپتامبر سال ۱۹۲۸ بود. پس از تعطیلات دو هفتهای، الکساندر فلمینگ به آزمایشگاهش در بیمارستان سنتمری در لندن بازگشت. او شروع به مرتب کردن پتریهای دیشی کرد که حاوی کلنیهای باکتری بود. در حین انجام این کار، او متوجه وجود موردی غیرعادی در یکی از پتریها شد که اشتباها در کل این زمان درب آن باز مانده بود.
او شاهد رشد کپکی آبی-سبز در آن پتری دیش بود، اما ناحیهی اطراف کپکها عاری از باکتری بود. براساس این مشاهده، فلمینگ نتیجه گرفت که کپکها مادهای ترشح کردهاند که میکروارگانیسمها را مهار کرده یا میکشند. او بعدا نام این ماده را پنیسیلین نهاد. این کشف غیرمنتظره، تاریخچهی پزشکی مدرن را تغییر داد و پنیسیلین موجب نجات جان میلیونها بیمار عفونیشده با باکتریهای کشنده شد. بااینحال فلمینگ بهعنوان یک باکتریشناس میدانست که تکامل، فرایندی اجتنابناپذیر است و درنهایت باکتریها نسبتبه آنتیبیوتیک مقاوم میشوند.
پتری دیش اولیهای که الکساندر فلمینگ در آن پنیسیلین را برای اولین بار در سال ۱۹۲۸ کشف کرد
پیشبینی او درست بود، اولین پاتوژن مقاوم به پنیسیلین در سال ۱۹۴۰ شناسایی شد. از آن زمان به بعد، داروهای ضدباکتری زیادی معرفی شدند ولی با گذشت چندین سال از استفادهی بالینی از آنها، عوامل بیماریزای مقاوم به آن داروها نیز پدیدار شدند. پیدایش اخیر باکتری مقاوم به کارباپنمها از همه نگرانکنندهتر است، زیرا این دارو آخرین خط دفاعی شناختهشده علیه میکروبهایی است که نسبتبه چندین آنتیبیوتیک مقاوم شدهاند.
این یک نگرانی رو به رشد در کل جهان است. براساس گزارش مرکز پیشگیری و کنترل بیماریها فقط در آمریکا، عفونتهای باکتریایی مقاوم به دارو بیش از ۲۳ هزار فرد را هرساله به کام مرگ میفرستند و علاوهبر هزینههای مراقبتی مستقیم، سالانه هزینهای درحدود ۲۰ میلیارد دلار بر سیستم بهداشت این کشور تحمیل میکنند. متاسفانه کمبود شدید داروهای آنتیبیوتیک جدید در خطوط توسعه وجود دارد و بیشتر داروهایی که در حال حاضر مورد استفاده قرار میگیرند، انواع اصلاحشدهای از داروهای موجود هستند. این موضوع چالش بزرگی پیشروی پزشکانی است که عفونتهای شدید را درمان میکنند و منجر به ایجاد نگرانیهایی درمورد رسیدن عصر پس از آنتیبیوتیک شده است.
اما پیشرفتهای اخیر در دانش دانشمندان در زمینهی روابط میزبان-پاتوژن، دیدگاهی تازه در مورد رویکرد درمانی جایگزینی ایجاد کرده است که درمان مبتنی بر میزبان (HDT) نامیده میشود. درمانی مبتنی بر میزبان، مجموعهای از درمانها است که هدف آن بهجای تکیهی مطلق روی داروهای آنتیباکتریایی، تقویت پاسخ ایمنی میزبان است.
از مثالهای امیدبخش این رویکرد دارویی، برخی داروهای مورد استفاده برای داروهای غیرعفونی هستند. برای مثال وراپامیل و متفورمین که موجب تعدیل التهاب میشوند و پاسخ ضدمیکروبی میزبان را در برابر پاتوژنها افزایش میدهند؛ سیتوکینها، گروهی از پروتئینها که شامل اینترلوکینها هستند و باعث میشوند که سلولهای پیشالتهابی میزبان سیگنالی برای کشتن پاتوژنها تولید کنند و محصولات تغذیهای مانند ویتامین D3 که موجب تقویت سیستم دفاعی میزبان میشود. علاوهبر این هدف این روش درمانی، ایجاد توازنی در واکنش بدن نسبتبه عفونت ازطریق کاهش یا پیشگیری از پاسخ التهابی شدیدی است که میتواند به اندامهای داخلی آسیب برساند و حتی کشنده باشد. این امر توسط درمان سلولی حاصل میشود که در آن جمعیت خاصی از سلولهای مغز استخوان درون بدن میزبان تزریق میشود.

در این زمینه، تمرکز پژوهشهای کنونی درک نقش عوامل میزبان در دفاع در برابر عفونتهای باکتریایی است. این امر همچنین در برگیرندهی بررسی درمورد اینکه چگونه عوامل میزبان در عمل تنظیم التهاب مشارکت میکنند، نیز است. برای بررسی این موضوع پژوهشگران بهدنبال بررسی اثر عوامل میزبان روی ژنهایی که سیتوکینها را تولید میکنند، هستند. همچنین از آنجایی که آهن نقش مهمی در رشد پاتوژن و التهاب دارد، پژوهشگران بهدنبال بررسی اثر عوامل میزبان روی ژنهایی که انتقال و متابولیسم آهن را تنظیم میکنند، هستند.
درک کامل اینکه چگونه این عوامل در دفاع میزبان و کنترل التهاب مشارکت دارند، در پزشکیِ شخصی میتواند بینهایت مهم باشد، جایی که صفات ژنتیکی بیمار میتوانند درمان عفونت را هدایت کنند. این تفاوتهای ظریف در DNA که پلیمورفیسم (چندشکلی) نامیده میشود، میتوانند توضیح دهند که چرا برخی از افراد نسبتبه برخی پاتوژنها حساستر از دیگران هستند. با شناسایی این پلیمورفیسمها و یافتن ارتباط هرکدام با سطوح حساسیت به پاتوژن، این پژوهشها میتواند منجر به طراحی درمانهای موثرتر در عفونتهای باکتریایی شود. درک ما از عوامل میزبان در پاسخ به عفونت هنوز در مراحل اولیه است؛ اما این دانش آغازگر ارائهی روشی جدید برای درمان یا پیشگیری از عفونتهای باکتریایی است که جان میلیونها نفر در جهان را میگیرند.